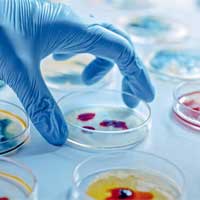

Saf Su Cihazları, Deiyonize Su Cihazları, Distile Su Cihazları, Ultra Saf Su Cihazları, deiyonizesafsu.tr de: +90 507 120 85 80
Laboratuvar ve sanayi uygulamaları için en ideal saf su cihazlarını tercih edin.
Analitik uygulamalar ve nano teknoloji üretimler için akredite ultra saf su cihazları
Endüstri, Gıda ve Hassas uygulamalar için deiyonize saf su cihazları
Ters Ozmos destekli teknolojimiz ile düşük enerjili ve güvenli distile saf su cihazları
Dünya da ilk ve tek 7. nesil elektromanyetik deiyonizasyon teknolojisi ile kararlı ve güçlü
USP ve WFI için yüksek saflıkta Enjeksiyon suyu üretimi
Konvansiyonel ihtiyaçlar için modüler ve taşınabilir mobil saf su cihazları
Diş hekimleri ve dental klinikler için lisanslı ve en iyi saf su cihazları
Whatsapp Destek
Saf Su Cihazları, Deiyonize Su Cihazları, Distile Su Cihazları, Ultra Saf Su Cihazları, deiyonizesafsu.tr de
Merhaba
Uzmanlarımız soru ve taleplerinizi en kısa sürede yanıtlayacaktır.